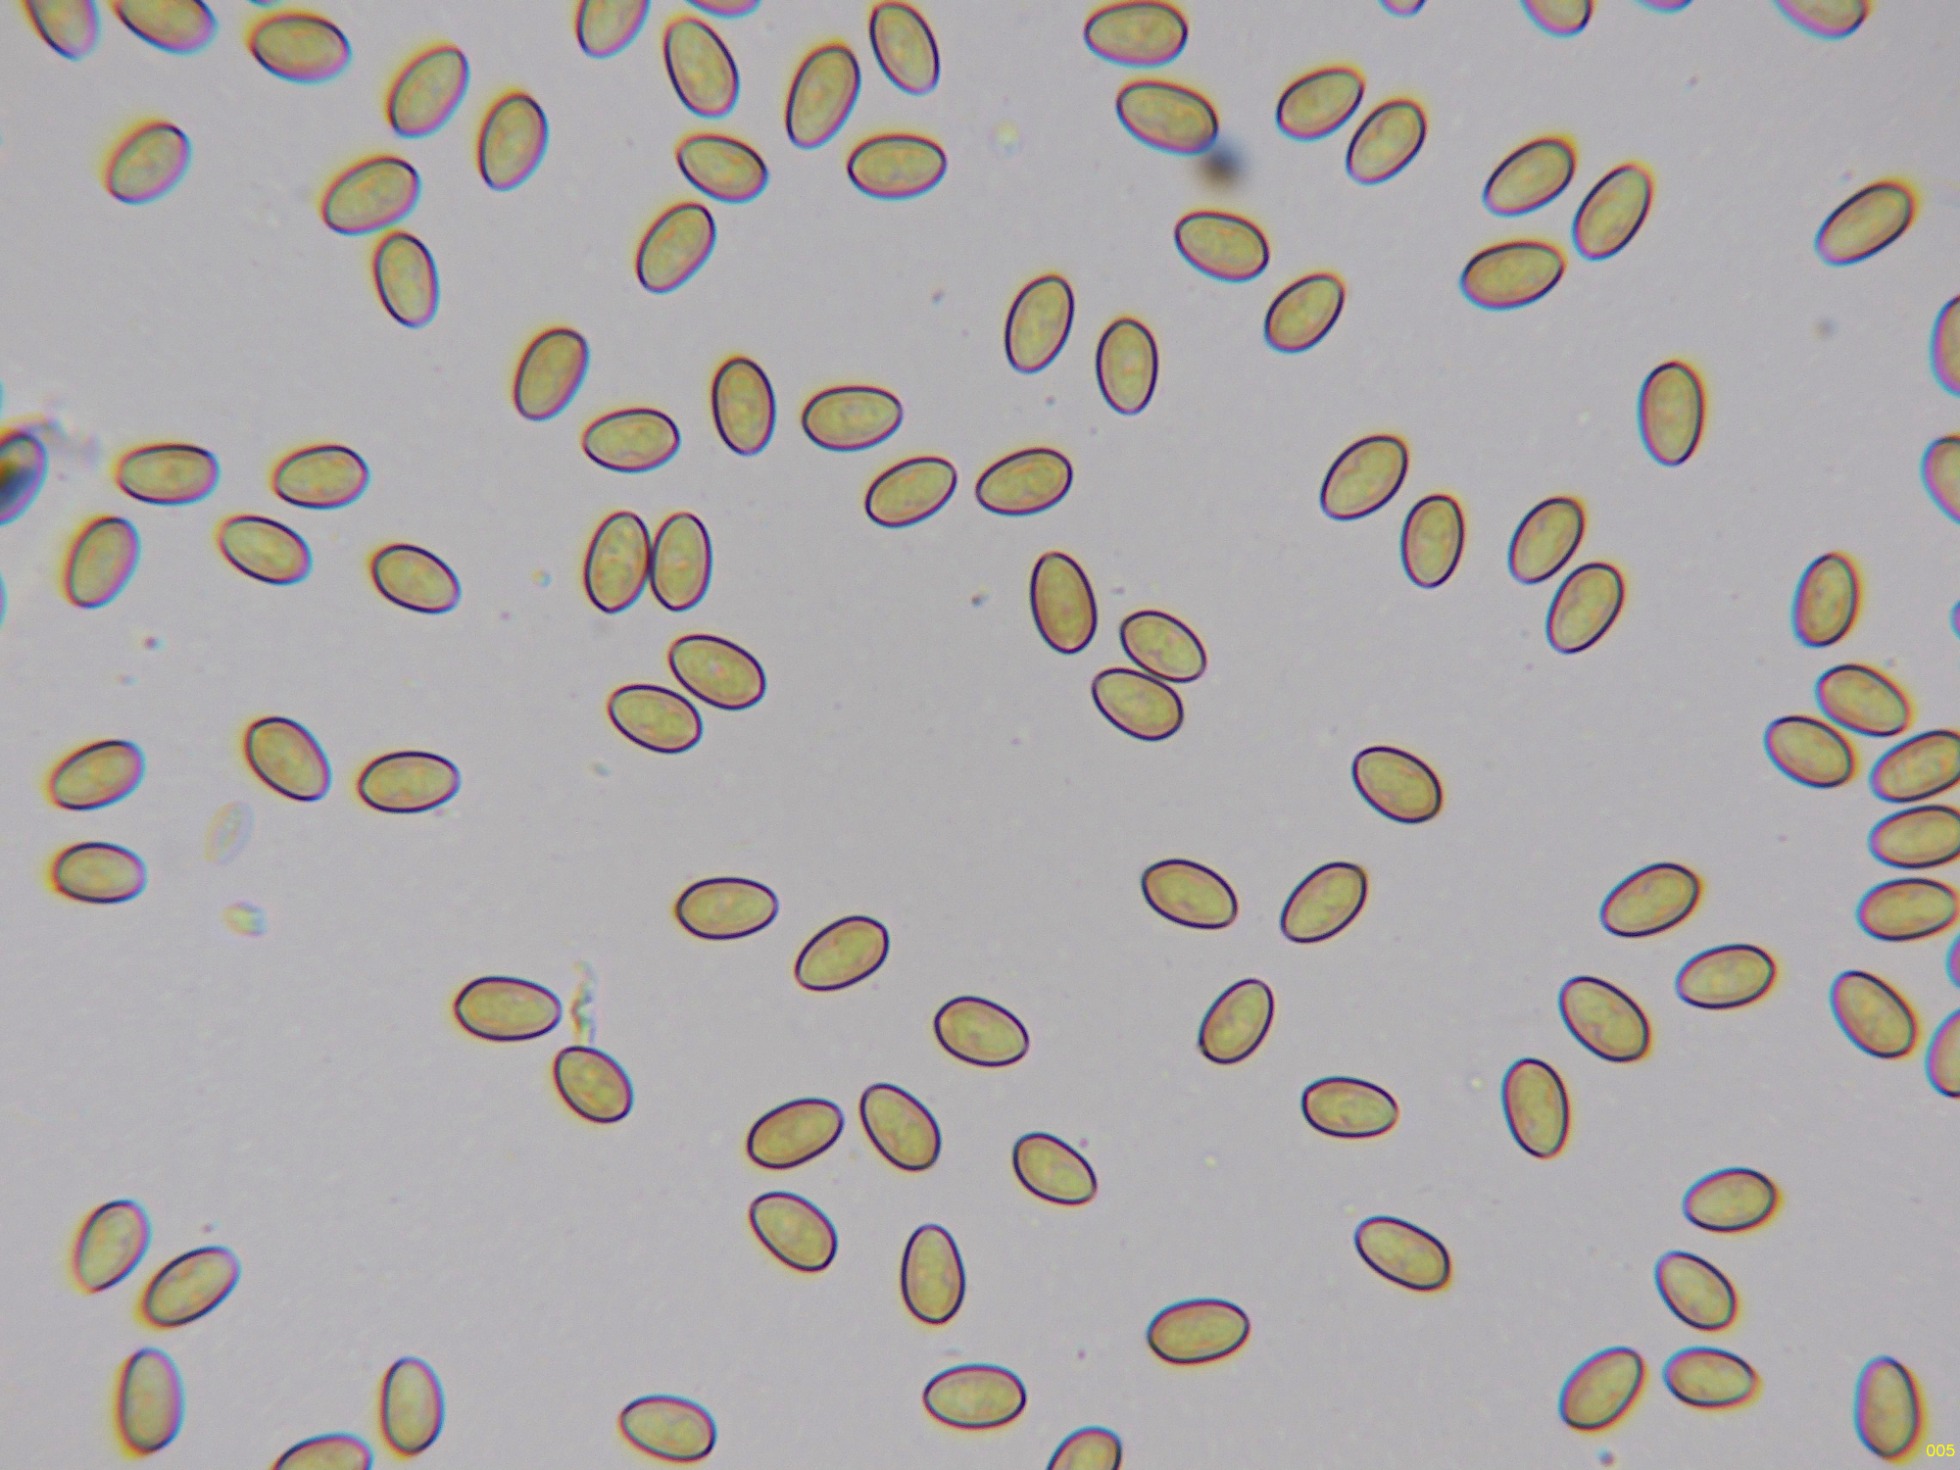

- Foro
- Foros sobre Micología de fungipedia
- Microscopía
- Pholiota highlandensis = Pholiota carbonaria (Fr.) Singer. Microscopía.
 Pholiota highlandensis = Pholiota carbonaria (Fr.) Singer. Microscopía.
Pholiota highlandensis = Pholiota carbonaria (Fr.) Singer. Microscopía.
- Josep Torres
-
 Autor del tema
Autor del tema
- Ausente
- Moderador
-

Menos
Más
- Mensajes: 8746
- Gracias recibidas: 8379
1 año 4 meses antes #110382
por Josep Torres
Hola.
Una Pholiota propia de quemados que se me resistía, admito que el día 6 si decidí visitar una zona quemada, aprovechando el momento de aparición, fue con la única intención de ya una vez por todas poder tachar el cromo, lo que se dice "llegar y besar el Santo", la había a cientos, sobre suelo carbonizado tenemos la:
Pholiota carbonaria (Fr.) Singer.
Syn: Pholiota highlandensis
Sección de la suprapellis a 400 aumentos:
En la parte más exterior de la suprapellis, una fina capa de hifas muy separadas por gelificación, que son las responsables de su cutícula viscosa:
Por debajo de estas una capa de hifas ya más compactadas, con incrustaciones y pigmento marrón ocráceo:
Por debajo de estas en la subpellis ya encontramos unas hifas más hialinas:
En la parte superior del pie se pueden observar unas escasas células terminales a modo de caulocistidios:
Las hifas del estípite:
Muy abundantes queilocistidios que dejan prácticamente estéril la arista laminar:
Pleurocistidios dispersos en la cara laminar con el extremo muy apuntado:
Los basidios de la cara laminar, tetraspóricos:
Una ampliación de estos basidios:
Las esporas en Reactivo de Melzer, sin prácticamente ninguna reacción aparente, inamiloides:
Y por último las esporas en agua:
Estas esporas obtenidas por esporulación natural y en agua con unas medidas de:
(6.2) 6.7 - 7.4 (7.7) × (4) 4.2 - 4.5 (4.7) µm
Q = (1.4) 1.5 - 1.7 (1.8) ; N = 40
Me = 7 × 4.3 µm ; Qe = 1.6
Saludos.
Una Pholiota propia de quemados que se me resistía, admito que el día 6 si decidí visitar una zona quemada, aprovechando el momento de aparición, fue con la única intención de ya una vez por todas poder tachar el cromo, lo que se dice "llegar y besar el Santo", la había a cientos, sobre suelo carbonizado tenemos la:
Pholiota carbonaria (Fr.) Singer.
Syn: Pholiota highlandensis
Sección de la suprapellis a 400 aumentos:
En la parte más exterior de la suprapellis, una fina capa de hifas muy separadas por gelificación, que son las responsables de su cutícula viscosa:
Por debajo de estas una capa de hifas ya más compactadas, con incrustaciones y pigmento marrón ocráceo:
Por debajo de estas en la subpellis ya encontramos unas hifas más hialinas:
En la parte superior del pie se pueden observar unas escasas células terminales a modo de caulocistidios:
Las hifas del estípite:
Muy abundantes queilocistidios que dejan prácticamente estéril la arista laminar:
Pleurocistidios dispersos en la cara laminar con el extremo muy apuntado:
Los basidios de la cara laminar, tetraspóricos:
Una ampliación de estos basidios:
Las esporas en Reactivo de Melzer, sin prácticamente ninguna reacción aparente, inamiloides:
Y por último las esporas en agua:
Estas esporas obtenidas por esporulación natural y en agua con unas medidas de:
(6.2) 6.7 - 7.4 (7.7) × (4) 4.2 - 4.5 (4.7) µm
Q = (1.4) 1.5 - 1.7 (1.8) ; N = 40
Me = 7 × 4.3 µm ; Qe = 1.6
Saludos.
Adjuntos:
El siguiente usuario dijo gracias: Juan Andrés Román
Por favor, Identificarse para unirse a la conversación.
- Foro
- Foros sobre Micología de fungipedia
- Microscopía
- Pholiota highlandensis = Pholiota carbonaria (Fr.) Singer. Microscopía.
Tiempo de carga de la página: 0.236 segundos

Foro de micología